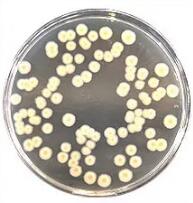

海博微信公众号
海博微信公众号
 海博天猫旗舰店
海博天猫旗舰店


 海博微信公众号
海博微信公众号
 海博天猫旗舰店
海博天猫旗舰店




“椰毒假单胞菌”,全称椰毒假单胞酵米面亚种Pseudomonas cocovenenans subsp.Farinofermentans,是—种存在于酵米面、变质鲜银耳及其他淀粉类发酵产品中的食源性致病菌。
由于椰毒假单胞酵母菌酵米面亚种不是国际公开发表和承认的细菌分类科学名称,1999年划分为唐菖蒲伯克霍尔德氏菌Burkholderiagladioli的一个病原型,目前现行标准GB/T 4789.29-2003《食品卫生微生物学检验椰毒假单胞菌酵米面亚种检验》。2018年9月国家卫生健康委员会发布的《食品安全国家标准食品微生物学检验唐菖蒲伯克霍尔德氏菌(椰毒假单胞菌酵米面亚种)检验(征求意见稿)》中,将该菌进行更名,同时新增分离培养基mPDA同PCFA用于唐菖蒲伯克霍尔德氏菌(椰毒假单胞菌酵米面亚种)的分离。
唐菖蒲伯克霍尔德氏菌检验流程图

一、前增菌以及选择性分离过程
前增菌:
淀粉类食品25g+225mLGVC增菌液,均质混匀,36土1℃,24-48h。
鲜银耳1g+20mL GVC增菌液,均质混匀,36土1℃,24-48h。
分离:
用直径3mm的接种环取增菌液一环,分别划线接种于mPDA平板和PCFA平板,36℃±1℃培养24 h~48 h。观察各个平板上生长的菌落。
|
|
|
|
mPDA平板 |
PCFA平板 |
|
24-48h,紫色、光滑、湿润、边缘整齐 培养48h后,部分菌落中心可有凸起呈草帽状 |
24-48h,灰白色,光滑、湿润、边缘整齐 |
二、初筛实验
自选择性琼脂平板上分别挑取5个以上典型或可疑菌落,分区划线卵黄琼脂平板,36℃±1℃培养。
挑取培养18~24 h的菌落进行革兰氏染色及氧化酶试验。对于革兰氏染色阴性、氧化酶试验阴性的菌继续培养至48 h±2 h。
对于卵磷脂酶阳性,带有虹彩环的单个菌落,接种PDA平板,36℃±1℃培养24 h±2 h。
|
|
|
|
|
卵黄琼脂(卵磷脂酶试验) |
PDA平板 |
|
|
培养24h后,菌落2mm~3mm,表面光滑、湿润,培养48h后,菌落周围形成乳白色混浊环,斜射光下可见菌落及周围培养基表面呈虹彩现象。 (通常需培养3-4d才看到明显特征) |
36土1℃,24-48h,菌落灰白或乳白色,光滑,边缘整齐,中心有凸起,呈草帽状。 |
三、生化试验
从纯培养的PDA平板上挑取菌苔进行生化鉴定。唐菖蒲伯克霍尔德氏菌生化特征见下表。可选择生化鉴定试剂盒或微生物生化鉴定系统。
|
生化试验 |
特 征 |
|
O/F 试验(氧化型) |
+ |
|
葡萄糖 |
+ |
|
果糖 |
+ |
|
木糖 |
+ |
|
半乳糖 |
+ |
|
蔗糖 |
- |
|
阿拉伯糖 |
+ |
|
甘露醇 |
+ |
|
侧金盏花醇 |
+ |
|
肌醇 |
+ |
|
卫茅醇 |
+ |
|
动力 |
+ |
|
卵磷脂酶 |
+ |
|
氧化酶 |
- |
|
尿素 |
+ |
|
明胶液化 |
+ |
|
硝酸盐还原 |
+ |
|
柠檬酸盐利用 |
+ |
|
精氨酸 |
+ |
|
石蕊牛乳 |
+ |
|
靛基质 |
- |
|
V-P |
- |
|
MR |
- |
|
苯丙氨酸脱氨酶 |
- |
|
H2S 产生 |
- |
|
注:+表示阳性;-表示阴性。 |
|
唐菖蒲伯克霍尔德氏菌检验用培养基列表
|
用途 |
货号 |
名称 |
规格 |
|
增菌 |
HB8591 | GVC增菌液 |
250g |
|
分离 |
HB9153 | 改良马铃薯葡萄糖琼脂(mPDA) |
250g |
| HB9153a | 氯霉素溶液 |
1ml*5支 |
|
| HB9153b | 龙胆紫溶液 | 1ml*5支 | |
| HB9140 | PCFA培养基 | 250g | |
| HB9140a | PCFA培养基添加剂 | 1ml*5支 | |
|
初筛 |
HB0262 | 卵黄琼脂培养基基础 | 250g |
| HB8295 | 50%卵黄乳液 | 5ml*10支 | |
| HB2100 | 氧化酶试纸 | 10片 | |
| HB8278 | 革兰氏染色液 | 5ml*8 | |
|
纯化 |
HB0233 | 马铃薯葡萄糖琼脂 | 250g |
|
产毒培养 |
HB0233-2 | 马铃薯葡萄糖半固体琼脂 | 250g |
|
生化鉴定 |
GB049 | OF生化管 | 20支 |
| GB117 | 葡萄糖 | 20支 | |
| GB144-1 | 果糖 | 20支 | |
| GB032 | 木糖 | 20支 | |
| GB152 | 半乳糖 | 20支 | |
| GB163 | 阿拉伯糖 | 20支 | |
| GB169 | 蔗糖 | 20支 | |
| 侧金盏花醇 | 20支 | ||
| GB007 | 甘露醇 | 20支 | |
| GB105 | 肌醇 | 20支 | |
| GS008 | 卫茅醇 | 20支 | |
| GB008 | 半固体琼脂 | 20支 | |
| GS004 | 尿素 | 20支 | |
| SN039 | 明胶生化管 | 20支 | |
| SN047 | 硝酸盐还原 | 20支 | |
| GS011 | 西蒙氏枸橼酸盐 | 20支 | |
| 精氨酸 | 20支 | ||
| HB8801 | 石蕊牛奶培养基 | 250g | |
| GS001 | 蛋白胨水 | 20支 | |
| GS003 | MR-VP生化管 | 20支 | |
| GB095 | 苯丙氨酸脱氨酶 | 20支 | |
| GB095a | 苯丙氨酸指示剂 | 5ml*4 | |
| GB065 | 硫化氢 | 20支 |
上一篇:肠球菌致病机制
下一篇:没有了!



